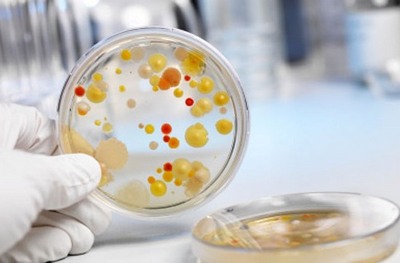

Фронтит — это воспалительное заболевание пазух (синусов) лобной кости человека. Это заболевание возникает по инфекционным причинам, то есть вызывается микроорганизмами. Механизм развития патологии связан вначале с воспалительными заболеваниями полости носа – ринитами.

Содержимое синуса довольно редко самостоятельно рассасывается, что и объясняет хроническое и тяжелое течение не только гайморитов, но и фронтитов.
Полость лобной пазухи связана с полостью носа небольшими отверстиями. Полость пазухи выстилает слизистая оболочка, подобная той, которая находится в носу. Это и объясняет активное развитие инфекционного процесса при попадании возбудителя внутрь пазухи.
Возбудителем воспалительного процесса пазухи лобной кости служат бактерии, которые чаще всего поражают верхние дыхательные пути – стрептококки, стафилококки, пневмококки и т.д.
Вирусная инфекция, часто приводит к бактериальным осложнениям ринита, что также может приводить к фронтиту взрослых и детей.
Основные принципы
Современна медицинская наука, при лечении фронтита, у взрослых и детей, опирается на несколько основных принципов:
Дренирование полости пазухи. Древний хирургический принцип гласит – «Где гной — там вскрой». Такая процедура необходима, чтобы освободить пазуху от гнойного процесса, обеспечить ее аэрацию, тем самым ликвидировать источник инфекции.
В отличие от мягких тканей, где гнойный процесс лечится специальным разрезом кожи, дренирование и лечение фронтальных пазух проводится лор-врачем, с помощью специального инструментария, который делает дополнительные отверстия в кости и удаляет содержимое фронтальных синусов. Также такая процедура препятствует новому скоплению гноя в полости синусов и делает лечение более эффективным.
-
Применение антибактериальных препаратов. Поскольку причиной инфекционного процесса в пазухах носа служат бактерии то для подавления их активного роста и размножения применяют антибактериальные средства. Выбор антибиотика проводится исходя из таких рекомендаций:
- При неизвестном возбудителе, спектр действия антибиотика должен охватывать максимальное число микроорганизмов.
Вначале лечения необходимо применять максимально эффективные дозы препарата, тем самым достигая высокой концентрации лекарства в крови. Это достигается внутривенным или внутримышечным введением антибактериального средства. В дальнейшем форма препарата меняется на более удобные для пациента таблетки и лечение продолжается.
- Курс лечения противомикробными средствами должен быть не менее 10-14 дней, даже при условии облегчения состояния больного и при исчезновении клинических признаков фронтита.
- Дозировка и кратность приема лекарства должна рассчитывается индивидуально, в зависимости от сопутствующих заболеваний, тяжести процесса. Также обязательно должно быть учтено наличие аллергии или непереносимости антибиотика конкретной группы.
- Симптоматическое лечение. Включает в себя жаропонижающие, обезболивающие средства, а также сосудосуживающие капли в нос. Эти препараты снимают симптомы заболевания и облегчают процесс лечения.
Посев. По возможности или в случае хронического течения фронтита и неэффективности эмпирической антибиотикотерапии, обязательно должен быть назначен посев гнойного отделяемого из пазухи носа на питательную среду, с последующим установлением чувствительности микроорганизма к антибиотикам.
Этот анализ позволит в скором времени более точно подобрать антибактериальный препарат, который максимально бы эффективно угнетал рост и размножения возбудителя заболевания. Применение антибиотика с более узким спектром действия делает лечение более эффективным.

Врачи подчеркивают, что антибиотики в терапии фронтита применяются только в случае бактериальной инфекции. При вирусной природе заболевания их использование нецелесообразно, так как это не приведет к улучшению состояния пациента и может вызвать побочные эффекты. Основные показания для назначения антибиотиков включают наличие гнойного отделяемого, выраженные симптомы интоксикации и отсутствие улучшения при консервативной терапии в течение нескольких дней. Важно, чтобы выбор антибиотика основывался на результатах микробиологического исследования, что позволяет более точно определить возбудителя и его чувствительность к препаратам. Врачам рекомендуется также учитывать индивидуальные особенности пациента, такие как наличие аллергий и сопутствующих заболеваний, чтобы минимизировать риск осложнений.

Применение антибактериальных средств
Для лечения фронтита сначала применяют антибактериальные средства широкого спектра действия таких фармакологических групп:
-
Пенициллины. Препараты этой группы обладают широким спектром противомикробной активности.
Однако за годы использования в медицинской практике, очень много бактерий выработали фермент, способны разрушат собственно молекулу пенициллина. Поэтому современными препаратами группы пенициллинов считаются те, которые защищены клавулановой кислотой.
Один из самых популярных препаратов этой группы служит препарат Амоксиклав. Средняя цена на упаковку таблеток этого препарата в Москве и Санкт-Петербурге колеблется от 220 до 300 рублей.
Цефалоспорины. Антибиотики широкого спектра, которые обладают сильным действием на многие бактерии, которые вызывают фронтит. Являются довольно популярными антибиотиками среди врачей.
Однако именно несоблюдение лечения полным курсом, таким сильным препаратом и приводит к развитию устойчивости (резистентности) микробной флоры к этому препарату. Средняя цена флакона препарата, содержащего 1 г. Цефтриаксона в Москве и СПб, в зависимости от производителя, колеблется от 30 до 100 рублей.
-
Фторхинолоны. Сильные антибактериальные препараты, но более узкого спектра действия по сравнению с пенициллинами и цефалоспоринами.
Однако, несмотря на это, спектр действия фторхинолонов включает практически все известные на сегодня бактерии, которые становятся причинами воспалительных процессов в лор-органах.
Самым популярными фармакологическими препаратами этой группы являются Ципрофлоксацин и Офлоксацин. Средняя цена упаковки препарата из 10 таблеток Ципрофлоксацина в Москве и СПб, в зависимости от производителя, колеблется от 20 до 40 рублей.
Антибиотики других фармакологических групп применяются гораздо реже, в случае устойчивости микрофлоры к указанным выше группам противомикробных средств. Также препараты других групп, которыми будет проводиться лечение, могут назначаться по результатам посева и тестирования микроорганизмов на устойчивость к антибиотикам.
Антибиотики играют важную роль в лечении фронтита, особенно когда заболевание вызвано бактериальной инфекцией. Многие пациенты отмечают, что назначение антибиотиков значительно ускоряет процесс выздоровления, особенно если симптомы, такие как сильная боль в области носа и гнойные выделения, сохраняются более недели. Однако важно понимать, что антибиотики неэффективны при вирусных инфекциях, которые также могут вызывать фронтит. В таких случаях врачи рекомендуют симптоматическое лечение, включая деконгестанты и обезболивающие. Некоторые люди выражают обеспокоенность по поводу побочных эффектов антибиотиков, таких как дисбактериоз, и подчеркивают необходимость их разумного применения. Врачи же акцентируют внимание на том, что самолечение может привести к осложнениям и развитию резистентности бактерий. Поэтому важно следовать рекомендациям специалиста и не забывать о профилактических мерах.
Противопоказания для применения
Человеку, болеющему фронтитом, важно понимать, что антибиотики — это сильные препараты, которые метаболизируются печенью и почками.

Также врачу важно учитывать факт наличия аллергии к антибиотику или индивидуальной непереносимости препарата или его компонентов. Аллергия чаще всего сопровождает человека при приеме препаратов группы пенициллинов.
Индивидуальная непереносимость может возникать при приеме любого антибиотика, и выражается в аномальных реакциях организма – тошноте и рвоте, эмоциональном и психическом возбуждении или угнетении. Поэтому первые приемы препарата проводятся под надзором врача в условиях стационара при лечении фронтита.

Вопрос-ответ
Нужен ли антибиотик при фронтите?
Антибиотики играют ключевую роль в терапии бактериального фронтита, особенно когда заболевание прогрессирует или не поддается стандартному лечению. После тщательной диагностики и подтверждения бактериальной природы фронтита врач может назначить антибиотики.
Какой антибиотик используется при фронтите?
Согласно рекомендациям Американской академии отоларингологии и хирургии головы и шеи, амоксициллин с клавуланатом или без него должен быть препаратом первой линии антибактериальной терапии при наличии показаний к применению антибиотиков. Если после 3–5 дней терапии улучшение не наступает, следует подтвердить наличие синусита.
Сколько дней нужно колоть антибиотики при фронтите?
При остром фронтите назначаются антибиотики в течение 7-10 дней. Выбор препарата зависит от его переносимости и тяжести заболевания.
Можно ли вылечить фронтит без антибиотиков?
Лечение хронического фронтита заключается в назначении сосудосуживающих капель для облегчения оттока гнойного содержимого из пазух, а также в использовании физиотерапевтических методик: УВЧ, электрофореза, галотерапии и других. Кроме этого, показана общеукрепляющая и иммуномодулирующая терапия.
Советы
СОВЕТ №1
Перед началом лечения антибиотиками обязательно проконсультируйтесь с врачом. Самолечение может привести к неправильному выбору препарата и ухудшению состояния.
СОВЕТ №2
Обратите внимание на симптомы фронтита. Антибиотики применяются только в случае бактериальной инфекции, поэтому важно провести диагностику и определить природу заболевания.
СОВЕТ №3
Следуйте предписаниям врача и не прекращайте курс антибиотиков преждевременно, даже если симптомы исчезли. Это поможет избежать развития устойчивости бактерий к лечению.
СОВЕТ №4
Обратите внимание на возможные побочные эффекты антибиотиков. Если вы заметили необычные реакции организма, немедленно сообщите об этом врачу для корректировки лечения.

 Вначале лечения необходимо применять максимально эффективные дозы препарата, тем самым достигая высокой концентрации лекарства в крови. Это достигается внутривенным или внутримышечным введением антибактериального средства. В дальнейшем форма препарата меняется на более удобные для пациента таблетки и лечение продолжается.
Вначале лечения необходимо применять максимально эффективные дозы препарата, тем самым достигая высокой концентрации лекарства в крови. Это достигается внутривенным или внутримышечным введением антибактериального средства. В дальнейшем форма препарата меняется на более удобные для пациента таблетки и лечение продолжается.